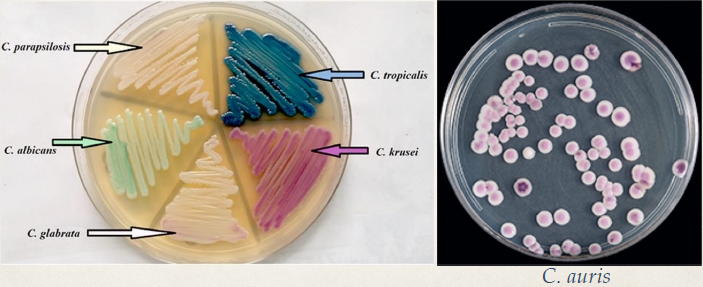
✤ Normal flora of the GI tract and often colonized the skin and the environment.

EPID851 Microbio
0.0(0)
Card Sorting
1/285
Earn XP
Last updated 4:02 AM on 4/11/23
Name | Mastery | Learn | Test | Matching | Spaced | Call with Kai |
|---|
No analytics yet
Send a link to your students to track their progress
286 Terms
1
New cards
crystal violet stain
the primary stain used in gram staining that causes the purple colour in gram-positive bacteria
2
New cards
gram stain
A method for the differential staining of bacteria that involves fixing the bacterial cells to a slide and staining with crystal violet and iodine, then washing with alcohol, and counterstaining with safranin. Results in gram-positive bacteria retaining the purple dye and gram-negative organisms having it decolourized so that the red counterstain shows up.
- developed in 1882 by Hans Cristian Gram
- developed in 1882 by Hans Cristian Gram
3
New cards
gram positive
- Describing the group of bacteria that have a cell wall that is structurally less complex and contains more peptidoglycan than the cell wall of gram-negative bacteria (thicker peptidoglycan layer).
- the thick cell wall (peptidoglycan layer) is cross-linked between N-acetyl Glutamine (NAG) and N-acetyl Muramic acid (NAM)
- Gram-positive bacteria are usually less toxic than gram-negative bacteria.
- the thick cell wall (peptidoglycan layer) is cross-linked between N-acetyl Glutamine (NAG) and N-acetyl Muramic acid (NAM)
- Gram-positive bacteria are usually less toxic than gram-negative bacteria.
4
New cards
gram negative
- Describing the group of bacteria that have a cell wall that is structurally more complex and contains *less peptidoglycan* than the cell wall of gram-positive bacteria.
- They have outer and inner cell membranes.
- outer membrane composed of lipopolysaccharides (LPS) endotoxin
- Between the cell membrane and the peptidoglycan layer is the peri-plasmic space.
- Gram-negative bacteria are often more toxic than gram-positive bacteria.
- They have outer and inner cell membranes.
- outer membrane composed of lipopolysaccharides (LPS) endotoxin
- Between the cell membrane and the peptidoglycan layer is the peri-plasmic space.
- Gram-negative bacteria are often more toxic than gram-positive bacteria.
5
New cards
mycobacteria
acid-fast bacteria; gram stain does not stain (thick cell wall is not penetrable) --\> therefore not gram positive or negative; determined by the Zeihl-Neilson stain; ex. TB and leprosy
- thick membrane capsule and mycolic acid cell wall that make them impermeable to most things
- thick membrane capsule and mycolic acid cell wall that make them impermeable to most things
6
New cards
mycoplasma
bacteria that lack cell walls
- respiratory infections
- simplest of bacteria: no peptidoglycan layer, only lipoprotein membrane
- cannot be stained by any stain (gram or otherwise)
- cannot be seen under microscopes
- respiratory infections
- simplest of bacteria: no peptidoglycan layer, only lipoprotein membrane
- cannot be stained by any stain (gram or otherwise)
- cannot be seen under microscopes
7
New cards
Lipopolysaccharide
complex of lipid and polysaccharide responsible for symptoms of fever and shock; potent immune responders; found in gram negatives
8
New cards
bacteria
- Domain of unicellular prokaryotes that have cell walls containing peptidoglycan
- cytoplasm with no nucleus
- ribosomes for metabolic activity
- contain both DNA and RNA
- reproduce by binary fission
- colonize the skin, gut, mouth, hair, and genital tract
- cytoplasm with no nucleus
- ribosomes for metabolic activity
- contain both DNA and RNA
- reproduce by binary fission
- colonize the skin, gut, mouth, hair, and genital tract
9
New cards
bacteria shapes
cocci, bacilli, spirilla, curved
10
New cards
cocci
spherical bacteria
kokkos (greek) \= grain, seed, berry
kokkos (greek) \= grain, seed, berry
11
New cards
bacilli
Rod shaped bacteria
baculum (latin) \= walking stick or a small staff
baculum (latin) \= walking stick or a small staff
12
New cards
spirilla
spiral-shaped bacterial cells
13
New cards
bacterial cell membrane
- composed of a phospholipid bilayer (as in eukaryotes); functions as a semipermeable barrier for cell; is capable of making cell wall repairs by filling in damaged areas with new PG or LPS
- energy production
- nutrient procession
- transport of nutrients & waste
- selective transport of molecules
- secretion site of toxins and enzymes
- osmotic barrier
- energy production
- nutrient procession
- transport of nutrients & waste
- selective transport of molecules
- secretion site of toxins and enzymes
- osmotic barrier
14
New cards
medically relevant gram positives
staphylococci, streptococci, single cocci
15
New cards
staphylococcus
a genus of gram-positive bacteria that are highly pathogenic, causing local lesions and serious opportunistic infections
- 2 main groups: coagulase positive (S. aureus) and coagulase negative (all non S. aureus)
✤ Can cause infections - several medically serious infections.
✤ But also part of the normal flora of various areas of the body.
✤ ALWAYS important when found in sterile sites.
✤ Methicillin-Resistant S. aureus (MRSA) is a superbug.
- 2 main groups: coagulase positive (S. aureus) and coagulase negative (all non S. aureus)
✤ Can cause infections - several medically serious infections.
✤ But also part of the normal flora of various areas of the body.
✤ ALWAYS important when found in sterile sites.
✤ Methicillin-Resistant S. aureus (MRSA) is a superbug.
16
New cards
Coagulase negative staphylococci
aerobic, gram-positive coccus (occurring in clusters. Frequently found on the skin and mucous membranes)
✤ Few common coagulase-negative staphylococci - To name a few : S.epidermidis, S. hominus, S. warneri, S. hemolyticus, S.capitis.
✤ All of them are grouped together and are called Coagulase-negative
staphylococcus.
✤ Skin flora and not as medically important as Staphylococcus aureus.
✤ Can cause serious infections but typically represent opportunistic infections - few cause primary infections.
✤ Few common coagulase-negative staphylococci - To name a few : S.epidermidis, S. hominus, S. warneri, S. hemolyticus, S.capitis.
✤ All of them are grouped together and are called Coagulase-negative
staphylococcus.
✤ Skin flora and not as medically important as Staphylococcus aureus.
✤ Can cause serious infections but typically represent opportunistic infections - few cause primary infections.
17
New cards
Streptococci
bacteria that form a chain;
✤ Gram-positive and usually found in the mouth and the oropharynx.
✤ Typically organisms of low virulence.
✤ Classified based on how the organisms grow on blood agar (5% blood in the agar).
✤ Gram-positive and usually found in the mouth and the oropharynx.
✤ Typically organisms of low virulence.
✤ Classified based on how the organisms grow on blood agar (5% blood in the agar).
18
New cards
streptococci hemolysis patterns
✤ Alpha hemolysis - Partial lysis of blood cells in the agar (agar goes green)
✤ Beta-hemolysis - Complete lysis of blood cells in the blood agar.
✤ Gamma-hemolysis - Blood cells not lysed (not really hemolysis)
✤ Beta-hemolysis - Complete lysis of blood cells in the blood agar.
✤ Gamma-hemolysis - Blood cells not lysed (not really hemolysis)
19
New cards
Viridans Streptococci
✤ Not very pathogenic
✤ Part of the normal oral flora
✤ Part of the normal oral flora
20
New cards
Streptococcus pneumoniae
✤ Part of the normal oral flora.
✤ Pathogen associated with Community acquired pneumonia, Bacteremia, Meningitis, Otitis media
✤ Pathogen associated with Community acquired pneumonia, Bacteremia, Meningitis, Otitis media
21
New cards
gram positive bacilli
✤ Common environmental bacteria.
✤ Clinically important organisms in this group include Bacillus anthracis, Bacillus cereus, Listeria monocytogenes, Clostridium difficile, Clostridium perfringens, Clostridium tetani, Clostridium botulinum, Propionibacterium acnes
✤ Also includes several organisms that are found on your skin or environment
including Corynebacterium spp, non-anthracis Bacillus spp.
✤ Clinically important organisms in this group include Bacillus anthracis, Bacillus cereus, Listeria monocytogenes, Clostridium difficile, Clostridium perfringens, Clostridium tetani, Clostridium botulinum, Propionibacterium acnes
✤ Also includes several organisms that are found on your skin or environment
including Corynebacterium spp, non-anthracis Bacillus spp.
22
New cards
Listeria monocytogenes
✤ Associate most often with food-borne outbreaks - the last big outbreak in Canada was in 2008, with 57 cases, and 22 deaths related to contaminate Deli meats. ✤ Found in almost all soft cheeses, Deli meats. ✤ Can cause placentitis, amnionitis, pre-term labour, spontaneous abortions, and stillbirths - as listeria is able to cross the placenta and infect the fetus. ✤ Grows well at 4 degrees Celsius - Cold Amplification.
23
New cards
Clostridium spp.
✤ Organisms in the genus Clostridium are all anaerobes (grow in an oxygen-free environment)
✤ All of the organisms in this species form spores, which allow them to remain in the environment for long periods of time.
✤ Cause a number of infections including tetanus, botulism, anthrax, gas gangrene, gastroenteritis and bacteremia.
✤ Notable organisms in this genus include Clostridium difficile, Clostridium tetani, Clostridium botulinum, and Clostridium perfringens.
✤ All of the bacteria are prodigious toxin producers - their primary virulence factor.
✤ All of the organisms in this species form spores, which allow them to remain in the environment for long periods of time.
✤ Cause a number of infections including tetanus, botulism, anthrax, gas gangrene, gastroenteritis and bacteremia.
✤ Notable organisms in this genus include Clostridium difficile, Clostridium tetani, Clostridium botulinum, and Clostridium perfringens.
✤ All of the bacteria are prodigious toxin producers - their primary virulence factor.
24
New cards
gram negative bacilli
✤ Organisms found in a number of sites including fresh water, the gastrointestinal tract and the respire.
✤ Can lead to serious infections including blood, wound infections, and pneumonia.
✤ A major issue with these gram-negative bacilli is their resistance to antibiotics.
✤ Important organisms in this group include Escherichia coli, Pseudomonas aeruginosa, Klebsiella pneumoniae, Proteus mirabilis.
✤ Can lead to serious infections including blood, wound infections, and pneumonia.
✤ A major issue with these gram-negative bacilli is their resistance to antibiotics.
✤ Important organisms in this group include Escherichia coli, Pseudomonas aeruginosa, Klebsiella pneumoniae, Proteus mirabilis.
25
New cards
fermenters
lactose fermenter colonies: Escherichia coli Klebsiella pneumoniae Enterobacter cloacae Serratia marcescens Proteus vulgaris
26
New cards
non-fermenters
non-lactose fermenter colonies: Pseudomonas aeruginosa Acenitobacter baumanii Bordetella Burkholderia Stenotrophomonas
27
New cards
gram negative cocci
✤ Organisms found in the oral flora and mucosal surfaces including the genital tract.
✤ Organisms in this group can colonize the oral flora, but can also cause meningitis, pneumonia, bacteremia, and sexually transmitted infection.
✤ Medically important organisms in this group include Neisseria gonorrhoea, Neisseria meningitidis, Neisseria spp. (non gonorrhoea, non-meningitidis) are commonly found in the normal oropharynx.
✤ Organisms in this group can colonize the oral flora, but can also cause meningitis, pneumonia, bacteremia, and sexually transmitted infection.
✤ Medically important organisms in this group include Neisseria gonorrhoea, Neisseria meningitidis, Neisseria spp. (non gonorrhoea, non-meningitidis) are commonly found in the normal oropharynx.
28
New cards
viruses
✤ "Virus" latin meaning toxin or poison.
✤ Tiny obligate parasites. Unable to sustain themselves and do not replicate on their own.
✤ Made up of proteins and ONE type of Nucleic acid (either RNA or DNA).
✤ The main function of a virion (a singly virus molecule) is to deliver its DNA or RNA into the host cell so that it can be expressed (transcribed and translated) by the host cell.
✤ Can infect animal cells, bacteria (bacteriophages), human cells.
✤ Tiny obligate parasites. Unable to sustain themselves and do not replicate on their own.
✤ Made up of proteins and ONE type of Nucleic acid (either RNA or DNA).
✤ The main function of a virion (a singly virus molecule) is to deliver its DNA or RNA into the host cell so that it can be expressed (transcribed and translated) by the host cell.
✤ Can infect animal cells, bacteria (bacteriophages), human cells.
29
New cards
bacteria vs viruses
✤ Incredibly small - need an electron microscope to see them.
✤ Bacteria self-replicate - viruses do not.
✤ Bacteria have cellular machinery including ribosomes - viruses do not.
✤ Bacteria self-replicate - viruses do not.
✤ Bacteria have cellular machinery including ribosomes - viruses do not.
30
New cards
virus size
size is smaller than bacteria; measured in nm
31
New cards
virus outer structure
✤ The outer most portion of a virus
is its envelope made up of glycoproteins - but only some viruses are enveloped.
✤ The envelope of the virus is
made from proteins from the host cell.
✤ The Capsid is a protein shell the
protects the the nucleic acid of the virus.
is its envelope made up of glycoproteins - but only some viruses are enveloped.
✤ The envelope of the virus is
made from proteins from the host cell.
✤ The Capsid is a protein shell the
protects the the nucleic acid of the virus.
32
New cards
Capsid
✤ The capsid proteins are important for the attachment of viruses to specific host receptors.
✤ Viral Capsid:
• Protein shell provides structure and symmetry to the virus.
• Consists of assembly of identical
protein subunits.
• Capsids are either (1) Icosahedral
(2) Helical or (3) Spherical
✤ Viral Capsid:
• Protein shell provides structure and symmetry to the virus.
• Consists of assembly of identical
protein subunits.
• Capsids are either (1) Icosahedral
(2) Helical or (3) Spherical
33
New cards
virus classification system
✤ Virus Classification system includes:
I. Nature of the nucleic acid in the Virion (RNA or DNA)
II. Symmetry of the capsid (helical, icosahedral)
III.Presence or absence of an envelope(enveloped or naked).
IV. Structure, size and or Morphology of a virus.
V. Tissue or organ tropism (Adenovirus, Enterovirus, Rhinovirus).
I. Nature of the nucleic acid in the Virion (RNA or DNA)
II. Symmetry of the capsid (helical, icosahedral)
III.Presence or absence of an envelope(enveloped or naked).
IV. Structure, size and or Morphology of a virus.
V. Tissue or organ tropism (Adenovirus, Enterovirus, Rhinovirus).
34
New cards
virus replication cycle
✤ Steps of viral replication.
1. Attachment
2. Entry and uncoating
3. Replication and Assembly
4. Egress or Release of the virus.
1. Attachment
2. Entry and uncoating
3. Replication and Assembly
4. Egress or Release of the virus.
35
New cards
virion attachment
✤ Several mechanisms of viral entry including:
✤ Direct fusion
✤ Endocytosis (may be receptor mediate or not)
✤ Receptor mediate entry (HIV, Hep viruses)
✤ Nucleic acid translocation (rare)
✤ Direct fusion
✤ Endocytosis (may be receptor mediate or not)
✤ Receptor mediate entry (HIV, Hep viruses)
✤ Nucleic acid translocation (rare)
36
New cards
lytic cycle
a viral reproductive cycle in which copies of a virus are made within a host cell, which then bursts open, releasing new viruses
37
New cards
lysogenic cycle
a viral reproductive cycle in which the viral DNA is added to the host cell's DNA and is copied along with the host cell's DNA
38
New cards
dsDNA virus Replication
✤ The viral DNA is transcribed to viral mRNA by the VIRAL polymerase.
✤ The mRNA is then translated to make proteins and enzymes that allow for new virus particle production
✤ Uses the host RNA polymerase to make RNA (capsid proteins, DNA polymerase)
✤ The newly created DNA polymerase can then replicate the virus DNA.
ex.:
✤ Herpes Simplex Virus 1 and 2 (HSV-1, HSV-2)
✤ Cytomegalovirus (CMV)
✤ Varicella zoster virus (VZV)
✤ Epstein Barr virus (EBV)
✤ Hepatitis B virus
✤ Parvovirus B19
✤ The mRNA is then translated to make proteins and enzymes that allow for new virus particle production
✤ Uses the host RNA polymerase to make RNA (capsid proteins, DNA polymerase)
✤ The newly created DNA polymerase can then replicate the virus DNA.
ex.:
✤ Herpes Simplex Virus 1 and 2 (HSV-1, HSV-2)
✤ Cytomegalovirus (CMV)
✤ Varicella zoster virus (VZV)
✤ Epstein Barr virus (EBV)
✤ Hepatitis B virus
✤ Parvovirus B19
39
New cards
RNA Viral Replication
✤ Much simpler
✤ Some can act directly as mRNA and be read on the ribosome.
✤ Some more complex i.e: Must bring extra replicative enzymes with them.
✤ Some can act directly as mRNA and be read on the ribosome.
✤ Some more complex i.e: Must bring extra replicative enzymes with them.
40
New cards
RNA Viruses
✤ Rotavirus
✤ Poliovirus
✤ West Nile Virus (WNV)
✤ Influenza Virus (Flu Viruses)
✤ Hepatitis A virus (HAV)
✤ Human Immunodeficiency Virus (HIV)
✤ Hepatitis C virus (HCV)
✤ SARS-CoV-1 and SARS-CoV-2 (COVID-19)
✤ Poliovirus
✤ West Nile Virus (WNV)
✤ Influenza Virus (Flu Viruses)
✤ Hepatitis A virus (HAV)
✤ Human Immunodeficiency Virus (HIV)
✤ Hepatitis C virus (HCV)
✤ SARS-CoV-1 and SARS-CoV-2 (COVID-19)
41
New cards
Latent Viral Infection
✤ the persistence of viral genomes,
but not infectious visions, in host cells without the destruction of the infected cell.
✤ Herpes simplex virus and varicella-zoster virus established latency in sensory neurons.
✤ HIV-1 can avoid host immune responses and antiretroviral drugs through the latent infection of resting memory CD4(+) T cells.
but not infectious visions, in host cells without the destruction of the infected cell.
✤ Herpes simplex virus and varicella-zoster virus established latency in sensory neurons.
✤ HIV-1 can avoid host immune responses and antiretroviral drugs through the latent infection of resting memory CD4(+) T cells.
42
New cards
Integration of viral DNA
✤ For certain viruses, viral DNA can also become integrated within host cell DNA.
✤ This can lead to latent infection.
✤ The virus may start to replicate at later times.
✤ Triggers for reactivation include Stress, UV light, Hormones, Immune suppression as well as several UNKNOWN triggers.
✤ This can lead to latent infection.
✤ The virus may start to replicate at later times.
✤ Triggers for reactivation include Stress, UV light, Hormones, Immune suppression as well as several UNKNOWN triggers.
43
New cards
Negative sense (-) RNA Viruses
✤ Negative sense (-) RNA has to
be converted to a positive stranded genome prior to mRNA and protein
production.
✤ The virion associated RNA polymerase results in a positive sense RNA that can them be transcribed to
proteins.
be converted to a positive stranded genome prior to mRNA and protein
production.
✤ The virion associated RNA polymerase results in a positive sense RNA that can them be transcribed to
proteins.
44
New cards
positive sense (+) RNA Virus
✤ The RNA directly to mRNA
and can be used to make proteins.
✤ Examples of positive-sense
viruses include SARS-CoV-2 and other coronaviruses.
✤ No intermediary steps (see slide \#19).
and can be used to make proteins.
✤ Examples of positive-sense
viruses include SARS-CoV-2 and other coronaviruses.
✤ No intermediary steps (see slide \#19).
45
New cards
Retroviruses
✤ Reverse Transcriptase enzyme
creates a single strand of viral DNA complementary to the retroviral RNA.
✤ ssDNA copied to form complementary DNA
✤ dsDNA now enters the host cell nucleus a later infection results.
creates a single strand of viral DNA complementary to the retroviral RNA.
✤ ssDNA copied to form complementary DNA
✤ dsDNA now enters the host cell nucleus a later infection results.
46
New cards
virus detection
✤Direct detection with Electron Microscopy.
✤ Serology (look at the host's response to the virus)
✤Amplification of Nucleic Acid (PCR)
✤Antigen Detection.
✤ Serology (look at the host's response to the virus)
✤Amplification of Nucleic Acid (PCR)
✤Antigen Detection.
47
New cards
election microscopy
✤ Used more in the past when viruses were difficult to grow.
✤ Must use an Electron Microscope - impractical and not very sensitive.
✤ Can only tell you what family of viruses the virus is from not the actual virus.
✤ Must use an Electron Microscope - impractical and not very sensitive.
✤ Can only tell you what family of viruses the virus is from not the actual virus.
48
New cards
virus culture
✤ Growth in tissue culture
✤ Not all viruses can be cultured
✤ Slow (days to weeks)
✤ Requires specific cell lines and many different tissues types must be
inoculated.
✤ Cytopathic effect (CPE)
✤ Effects the virus infection has on
the appearance of cells in culture viewed by light microscopy after a patient specimen is inoculated onto the cell culture and the virus has had a chance to replicate.
✤ CPE tends to be fairly Non-specific.
✤ Not all viruses can be cultured
✤ Slow (days to weeks)
✤ Requires specific cell lines and many different tissues types must be
inoculated.
✤ Cytopathic effect (CPE)
✤ Effects the virus infection has on
the appearance of cells in culture viewed by light microscopy after a patient specimen is inoculated onto the cell culture and the virus has had a chance to replicate.
✤ CPE tends to be fairly Non-specific.
49
New cards
serologic response
✤ Detection of the immune response by the host against the infectious agent.
✤ Detecting specific immunoglobulin - Host antibody response
✤ Common ways of detecting viruses that have a very narrow window of viremia (West Nile Virus, Zika virus) and those that are not culturable (Hepatitis B virus)
✤ Often can also be used when the virus is at low levels soon after infection.
✤ Detecting specific immunoglobulin - Host antibody response
✤ Common ways of detecting viruses that have a very narrow window of viremia (West Nile Virus, Zika virus) and those that are not culturable (Hepatitis B virus)
✤ Often can also be used when the virus is at low levels soon after infection.
50
New cards
amplification of nucleic acids
✤ Polymerase Chain Reaction (this is how SARS-CoV-2 is detected).
✤ Find a specific segment of RNA or DNA.
✤ Find a specific segment of RNA or DNA.
51
New cards
Antigen Detection
✤ Direct test on a patient specimen.
✤ Detecting specific antigens (antigen \= antibody generator) of the particular organism you are looking for.
✤ Similar to a pregnancy test.
✤ Typically not as sensitive as a PCR test.
✤ Detecting specific antigens (antigen \= antibody generator) of the particular organism you are looking for.
✤ Similar to a pregnancy test.
✤ Typically not as sensitive as a PCR test.
52
New cards
yeast(s)
unicellular fungus; most yeasts don’t cause pneumonia except Cryptococcus
53
New cards
Mold
multicellular fungus
54
New cards
fungal characteristics
like all eukaryotic organisms, fungi contain membrane bound organelles; they have distinct organelles including mitochondria (cell generator), endoplasmic reticulum (manages cellular export), and a membrane-bound nucleus; sexual (molds) and asexual reproduction (yeasts generally by budding also seen in molds)
55
New cards
yeasts
✤ Yeast colonies look similar to bacterial colonies BUT they are NOT bacteria.
✤ Over 1500 different species in kingdom Fungi.
✤ They are unicellular EUKARYOTIC organisms.
✤ Unlike bacteria which have a fairly rudimentary cellular structure, yeast have much more sophisticated cellular machinery.
✤ Over 1500 different species in kingdom Fungi.
✤ They are unicellular EUKARYOTIC organisms.
✤ Unlike bacteria which have a fairly rudimentary cellular structure, yeast have much more sophisticated cellular machinery.
56
New cards
Fungal Cell Wall
✤ Cell Wall is made up of something called Ergosterol, similar to Cholesterol and is a primary sterol.
✤ Contains a Cell wall
✤ No peptidoglycan
✤ Major structure is Chitin.
✤ Exploited for diagnosis typically
✤ New drugs use the cell wall as a target.
✤ Contains a Cell wall
✤ No peptidoglycan
✤ Major structure is Chitin.
✤ Exploited for diagnosis typically
✤ New drugs use the cell wall as a target.
57
New cards
Fungal Cell Structures
✤ Fungal cell wall contains Ergosterol as the primary sterol (animal cell membranes contain cholesterol).
✤ Gives Shape to the fungi
✤ Gives them strength by protecting them from organic solvents and UV light.
✤ Secretes enzymes from their walls - able to hydrolyze sugars for nutrition.
✤ Gives Shape to the fungi
✤ Gives them strength by protecting them from organic solvents and UV light.
✤ Secretes enzymes from their walls - able to hydrolyze sugars for nutrition.
58
New cards
Fungal Reproduction
✤ Primary reproductive structures are called **Spores** or __**Conidia**__ (Fungi produce these in nutrient-poor media (need to starve the organism for it to reproduce the patterns))
✤ Classification gets complicated because based on Size, Shape, and Arrangement are all used to classify the organism.
✤ All pattern recognition!
✤ Classification gets complicated because based on Size, Shape, and Arrangement are all used to classify the organism.
✤ All pattern recognition!
59
New cards
Yeast Reproduction
budding
60
New cards
Medically Relevant Yeasts
✤ Candida app (\~ 200 spp). - Found in mostly immunocompromised individuals, high mortality rate
✤ Cryptococcus spp. (main type: Cryptococcus neoformans; second type: *Cryptococcus gatii*) - Animal waste has high N content because of ammonia (not converted to urea)
✤ Cryptococcus spp. (main type: Cryptococcus neoformans; second type: *Cryptococcus gatii*) - Animal waste has high N content because of ammonia (not converted to urea)
61
New cards
Candida spp
✤ Normal flora of the GI tract and often colonized the skin and the environment.
62
New cards
Clinical manifestations of Candida infections
✤ Colonizes the GI tract and can act as a source.
✤ All except for C. albicans harbour higher levels of antifungal resistance.
✤ Transmission typically represents environmental contamination.
✤ All except for C. albicans harbour higher levels of antifungal resistance.
✤ Transmission typically represents environmental contamination.
63
New cards
Risk factors for invasive Candida infections
Broad-spectrum antibiotics or long-term use make us more susceptible to *Candida* infections; critical illness, with particular risk among patients with long-term ICU stay; abdominal surgery, with particular risk among patients who have anastomotic leakages or have had repeat laparotomies; acute necrotizing pancreatitis; hematologic malignant disease; solid-organ transplantation; solid-organ tumors; neonates, particularly those with low birth weight, and preterm infants; use of broad-spectrum antibiotics; presence of central vascular catheter, total parenteral nutrition; hemodialysis; glucocorticoid use or chemotherapy for cancer; candida colonization, particularly if multifocal (colonization index >0.5 or corrected colonization index >0.4)
64
New cards
Resistance Phenotype of *C.auris*
\

65
New cards
Cryptococcus spp
✤ The most medically relevant species are Cryptococcus neoformans and Cryptococcus gattii.
✤ Typically do not cause infections - but can lead to disease/infection in those with altered immune status or underlying morbidity. Mortality rate: \~60%
✤ Found in soil and in dried animal faeces - specifically associated with bird poop or guano.
✤ Can lead to pneumonia, fungemia (disseminated), meningitis and cutaneous infection.
✤ Contains a large capsule around the yeast cell - helps it evade immune-mediated phagocytosis.
✤ Typically do not cause infections - but can lead to disease/infection in those with altered immune status or underlying morbidity. Mortality rate: \~60%
✤ Found in soil and in dried animal faeces - specifically associated with bird poop or guano.
✤ Can lead to pneumonia, fungemia (disseminated), meningitis and cutaneous infection.
✤ Contains a large capsule around the yeast cell - helps it evade immune-mediated phagocytosis.
66
New cards
medically relevant molds
✤ Dermatophytes (\~ 50 spp) - Hair, skin, and nails (depend on keratin as primary source), ex. Ringworm - not a worm but a fungal infection
✤ Zygomycetes - Lead to infections in immunocompromised individuals or environmental trauma (like tree branch stabbing or scrapes from the ground; Difficult to treat, multi-drug resistant
✤ Hyaline Molds - Common cause of respiratory infections especially in Cystic Fibrosis patients
✤ Dimorphic Fungi (6 spp) - Dimorphic such that they're both molds and yeasts
✤ Zygomycetes - Lead to infections in immunocompromised individuals or environmental trauma (like tree branch stabbing or scrapes from the ground; Difficult to treat, multi-drug resistant
✤ Hyaline Molds - Common cause of respiratory infections especially in Cystic Fibrosis patients
✤ Dimorphic Fungi (6 spp) - Dimorphic such that they're both molds and yeasts
67
New cards
Dimorphic Fungi
1. Histoplasma capsulatum
2. Blastomyces dermatiditis (Kingston is endemic to this type)
3. Coccidioides immitis (Vegas, Cali, Nevada, Texas, Arizona (sandstorms are the risk factor))
4. Paracoccidiodes brasilensis (South America)
5. Sporothrix schleferi (Gardens, near rose thorns)
6. Taloromyces marneffei (In southeast Asia, found in US veterans who came back from Vietnam)
Temperature-dependent dimorphism - Yeast at 37C, Mold at 25C.
Don’t need to be immunocompromised to get these, can cause pneumonia in any individual - especially immunocompromised individuals
68
New cards
Infection Classification
• Superficial or cutaneous mycoses
• Subcutaneous mycoses
• Systemic mycoses
• Opportunistic mycoses
• Subcutaneous mycoses
• Systemic mycoses
• Opportunistic mycoses
69
New cards
Histoplasma capsulatum
Dimorphic fungal infections
✤ Clinical presentation include fever, sweats, weight loss, fatigue, and respiratory symptoms.
✤ CNS involvement in 5% to 20% of cases of acute disseminated histoplasmosis, presenting as chronic meningitis.
✤ Disseminated diseases are rare but seen. If a plate is grown with histoplasma capsulatum then it can reach patients
✤ Clinical presentation include fever, sweats, weight loss, fatigue, and respiratory symptoms.
✤ CNS involvement in 5% to 20% of cases of acute disseminated histoplasmosis, presenting as chronic meningitis.
✤ Disseminated diseases are rare but seen. If a plate is grown with histoplasma capsulatum then it can reach patients
70
New cards
Blastomyces dermatitidis
✤ Presents as nonspecific febrile acute or chronic pulmonary disease mimicking community-acquired pneumonia (CAP) and/or malignancy.
✤ Ultimately to disseminated disease involving cutaneous, genitourinary, and bony lesions.
✤ Ultimately to disseminated disease involving cutaneous, genitourinary, and bony lesions.
71
New cards
Coccidioides immitis
✤ Pulmonary involvement and in most cases is asymptomatic.
✤ Symptomatic infection presents with fever, cough, and chest pain and may mimic CAP.
✤ Disseminated disease can occur locally with pleural or pericardial invasion or any organ of the body. Disseminated disease can involves cutaneous, genitourinary, and bony lesions.
✤ Symptomatic infection presents with fever, cough, and chest pain and may mimic CAP.
✤ Disseminated disease can occur locally with pleural or pericardial invasion or any organ of the body. Disseminated disease can involves cutaneous, genitourinary, and bony lesions.
72
New cards
Opportunistic Mycoses
✤ Fungi that are considered “non-pathogenic” but can cause significant illness in the immunocompromised, those with prosthetic / intravascular devices and hematologic malignancies (Can also colonize respirators or other medical tech).
✤ Commonly found in soil and in the environment.
✤ Opportunistic infections by molds can result in sinus infections, respiratory diseases and fungemia.
✤ Aspergillus is the most common invasive mold. Invasive aspergillosis has become the major cause of morbidity and mortality in immunocompromised patients, with mortality rates as high as 88%.
✤ Almost two thirds (61%) of patients with invasive aspergillosis have an underlying hematologic disease, or have undergone bone marrow transplantation (BMT).
✤ Commonly found in soil and in the environment.
✤ Opportunistic infections by molds can result in sinus infections, respiratory diseases and fungemia.
✤ Aspergillus is the most common invasive mold. Invasive aspergillosis has become the major cause of morbidity and mortality in immunocompromised patients, with mortality rates as high as 88%.
✤ Almost two thirds (61%) of patients with invasive aspergillosis have an underlying hematologic disease, or have undergone bone marrow transplantation (BMT).

73
New cards
Aspergillus species
✤ Opportunistic mold with a few hundred species.
✤ Approximately 20 species have been associated with clinical infections.
✤ Transmission of Aspergillus species is via fungal spores either as aerosols or contaminated products or biologics (Found in a manufacturing factory for injectable pain killers).
✤ Approximately 20 species have been associated with clinical infections.
✤ Transmission of Aspergillus species is via fungal spores either as aerosols or contaminated products or biologics (Found in a manufacturing factory for injectable pain killers).

74
New cards
Risk factors for invasive pulmonary Aspergillus infections
Is detrimental to immunocompromised individuals; risk factors in image

75
New cards
Mucorales (Zygomecetes) Molds
✤ Zygomycetes are fast growing fungi
characterized by primitive coenocytic (mostly aseptate) hyphae.
✤ Environmental fungi in soil, dung and vegetative matter.
✤ One of the features of this class of fungi is rapid growth, known as “lid-lifters”. (Grow very fast (within 48-72h), aerial mycetes - growing upwards)
✤ Extremely aggressive disease as the organism does not respect tissue planes including devastating rhino-orbital infections and wound infections.
characterized by primitive coenocytic (mostly aseptate) hyphae.
✤ Environmental fungi in soil, dung and vegetative matter.
✤ One of the features of this class of fungi is rapid growth, known as “lid-lifters”. (Grow very fast (within 48-72h), aerial mycetes - growing upwards)
✤ Extremely aggressive disease as the organism does not respect tissue planes including devastating rhino-orbital infections and wound infections.
76
New cards
Risk factors for invasive Mucor infections
diabetic patients, neutropenia patients, patients with haematological malignancies, increased serum iron, immunocompromised state due to organ transplantation, chronic corticosteroid treatment, hemochromatosis
77
New cards
Most common presentations of Mucor infections
rhino cerebral mucormycosis (RCM), rhino orbital (ROC), rhino maxillary (ROM)
78
New cards
anti-fungal therapies

79
New cards
Laboratory detection of Fungi
✤ Gram stain + additional stains from specimens - may see fungal elements (Doesn’t penetrate the cell wall).
✤ Culture on specialize media - Yeast take 1-3 days, Dermatophytes take 1-3 weeks and systemic fungi can take 3-6 weeks.
✤ Variety of stains used can help identify fungi.
✤ Culture on specialize media - Yeast take 1-3 days, Dermatophytes take 1-3 weeks and systemic fungi can take 3-6 weeks.
✤ Variety of stains used can help identify fungi.
80
New cards
fungal stains
* KOH - Dissolves tissue cells leaving the fungal cells intact
* Calcoflour stain; Binds to Chitin in the fungal cell walls.
* Silver Stain: Stains fungi black and provides a nice contrast. Typically stains proteins in the fungal cell wall
* Calcoflour stain; Binds to Chitin in the fungal cell walls.
* Silver Stain: Stains fungi black and provides a nice contrast. Typically stains proteins in the fungal cell wall
81
New cards
Prions
Changed the Central Dogma of Molecular biology
82
New cards
Cellular Prion Proteins (PrPc)
• Present in cytoplasm, cell walls
• Ascribed cellular functions in eukaryotic cells
• Normal prion proteins (PrPc) seem to be conserved; present in fungi, bacteria all the way up to mammals (including humans).
• PrPc are sensitive to proteases - which helps regulate (and prevent) their accumulation in cells.
• Proteins form the functional framework for most cells and tissues.
• Most of the time with proteins, structure governs function.
• Just like most cellular products - proteins must fold correctly, conform to a specific structure and then be cleared.
• Mis-folding can alter protein clearance mechanisms, when this happens - a pathogenic process involving protein aggregate formation can occur.
• Ascribed cellular functions in eukaryotic cells
• Normal prion proteins (PrPc) seem to be conserved; present in fungi, bacteria all the way up to mammals (including humans).
• PrPc are sensitive to proteases - which helps regulate (and prevent) their accumulation in cells.
• Proteins form the functional framework for most cells and tissues.
• Most of the time with proteins, structure governs function.
• Just like most cellular products - proteins must fold correctly, conform to a specific structure and then be cleared.
• Mis-folding can alter protein clearance mechanisms, when this happens - a pathogenic process involving protein aggregate formation can occur.
83
New cards
Benefits of Prion-like mechanisms
• Physiologic prion proteins may not have all the properties of a “bona fide” pathogenic prion.
• So still associated with structural changes….but may not be transmitted to daughter cells and sensitive to protease cleavage.
• Referred to as Prion Like Mechanisms (PriLIMs)
1. Melanin scaffolding (UV protection - preventing oxidative damage)
2. signal propagation
3. dynamic scaffolding of ribonucleoprotein granules
* bet-hedging in microorganisms - confer anti-fungal resistance but have a selective growth advantage.
• So still associated with structural changes….but may not be transmitted to daughter cells and sensitive to protease cleavage.
• Referred to as Prion Like Mechanisms (PriLIMs)
1. Melanin scaffolding (UV protection - preventing oxidative damage)
2. signal propagation
3. dynamic scaffolding of ribonucleoprotein granules
* bet-hedging in microorganisms - confer anti-fungal resistance but have a selective growth advantage.
84
New cards
sporadic conversion
a spontaneous type of prion disease conversion
85
New cards
acquired
a type of prion disease conversion; ex. some acquisition from the environment like mad cow disease
86
New cards
inherited
germline mutation, spontaneous conversion more likely; genetic factor in certain families
87
New cards
sporadic mutation
somatic mutation, spontaneous conversion more likely
88
New cards
scrapie
prion disease affecting sheep and goat
89
New cards
bovine spongiform encephalopathy, BSE, mad cow disease
prion disease affecting cattle
90
New cards
transmissible mink encephalopathy, TME
prion disease affecting mink
91
New cards
chronic wasting disease (CWD)
prion disease affecting white-tailed deer, elk, mule deer, moose
92
New cards
feline spongiform encephalopathy, FSE
prion disease affecting cats
93
New cards
exotic ungulate encephalopathy, EUE
prion disease affecting nyala, oryx, greater kudu
94
New cards
spongiform encephalopathy
prion disease in ostriches, not shown to be transmissible
95
New cards
Creutzfeldt-Jakob disease, CJD
prion disease in humans;
cause: prions that are not killed by standard methods for sterilizing surgical equipment
consequences: as prions build up in cells, the brain slowly shrinks and the tissue fills with holes until it resembles a sponge. Those affected lose the ability to think and move properly and suffer from memory loss. It is always fatal, usually within one year of onset of illness.
cause: prions that are not killed by standard methods for sterilizing surgical equipment
consequences: as prions build up in cells, the brain slowly shrinks and the tissue fills with holes until it resembles a sponge. Those affected lose the ability to think and move properly and suffer from memory loss. It is always fatal, usually within one year of onset of illness.
96
New cards
clinical manifestations of prion diseases
symptoms: mood disturbances (aggression or loss of interest), anxiety, depression, disinhibition, dysarthria (speech becomes slurred), memory and cognitive deficits, ataxia (unsteadiness), muscle paralysis, difficulty swallowing, seizures
97
New cards
unique (prion) pathogenesis
Transmission of a “pathogen” without transfer of genetic material - unlike any other pathogenic process
98
New cards
lessons from pathogenic prions
1. Only known infectious pathogens that are devoid of nucleic acid.
2. Manifested as acquired infections, genetic, or sporadic disorders - a very wide spectrum of clinical manifestations.
3. Prion diseases result from the accumulation of PrPsc, which has a very different conformation from the normal precursor protein, PrPc
4. Different PrPsc can be a variety of conformations, each seems to be associated with a specific disease.
99
New cards
IPAC for prions
• Prion proteins are very hardy molecules using normal methods of sterilization and sanitation for medical equipment is not sufficient.
• Resistant to proteases, UV light, detergents, alcohol, quaternary products etc.
• Resistant to proteases, UV light, detergents, alcohol, quaternary products etc.
100
New cards
Patients at risk of getting Iatrogenic CJD
• Recipients of human tissue derived pituitary hormone treatment (either growth hormone or gonadotrophin).
• Recipients of a dura mater graft
• Recipients of a corneal graft originating in a jurisdiction that does not require graft donors to be screened for neurological disease.
• Patients who have been exposed, via contact with instruments, to high-infectivity tissue of confirmed CJD patients.
• Recipients of a dura mater graft
• Recipients of a corneal graft originating in a jurisdiction that does not require graft donors to be screened for neurological disease.
• Patients who have been exposed, via contact with instruments, to high-infectivity tissue of confirmed CJD patients.